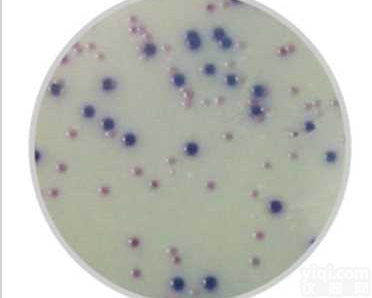
<em>大肠</em><em>杆菌</em>和<em>大肠</em>菌群显色培养基（CCA法，ISO标准）
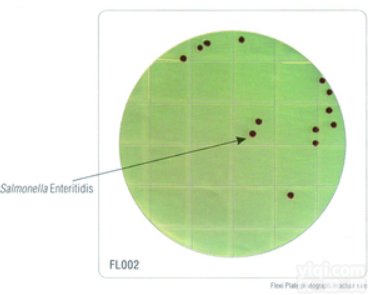
HiTouch™ <em>大肠</em><em>杆菌</em>和<em>大肠</em>菌群计数平板。
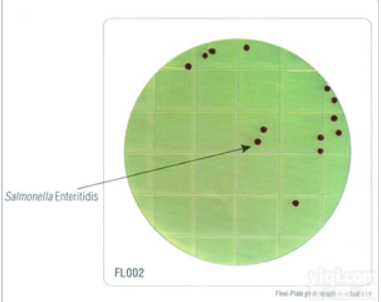
FL002  HiTouch™ <em>大肠</em><em>杆菌</em>和<em>大肠</em>菌群计数平板
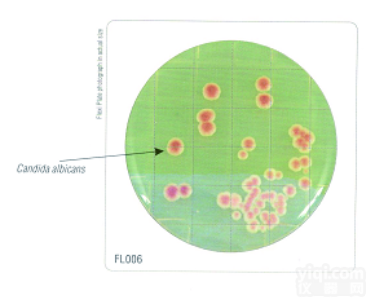
FL022  HiTouch™ <em>大肠</em><em>杆菌</em>和<em>大肠</em>菌群计数平板

吲哚试验( IND )检验方法 - 用IND缓冲液浸润IND测试条末端滤纸;
- 用接种环从适合的琼脂培养基上(不能用M-H琼脂、高葡萄糖含量或含染料的培养基上生长的菌落)挑取可疑待测菌落,在末端滤纸上涂抹开或直接蘸取菌落;
- 室温下20秒后观察测试条末端涂抹细菌处是否有蓝色产生。见下图。
公司介绍:重庆庞通YL器械有限公司创建于2000年,是一家致力于研制、生产与销售为一体的微生物检验试剂专业化公司,走产、学、研发展道路。我所处行业属于朝阳产业,国家ZD扶持对象。我们的产品广泛用于医院、卫生防疫、制药、食品、环保、饮料、奶制品等行业。
我们坚持以质量为生命,客户为上帝,不断推陈出新,为客户创造价值,为员工创造发展平台,为社会承担责任,为发展民族产业为己任。
我们的质量方针是:以质量为生,唯客户是命;周全服务事业成,推陈出新乾坤定。
公司地址:重庆市江北区港安二路48号曙光工业园C区7栋10楼
诚招代理: 重庆庞通诚招代理商,欢迎您的加入!
重庆庞通YL器械有限公司现面向全国诚招合作及代理商。欢迎全国各地代理商和客户来公司考察、采购。
我们坚持:以质量为生,唯客户是命;周全服务事业成,推陈出新乾坤定的质量方针。竭诚与您合作,携手并进,共铸辉煌!
联系我们:
欢迎大家咨询、订购我公司产品!
咨询热线:18323117760(闫小姐)/19923952477(小孟)
咨询QQ: 2171350473 /3366084970
电话:023-88613755
温馨提示:不可用于临床ZL。